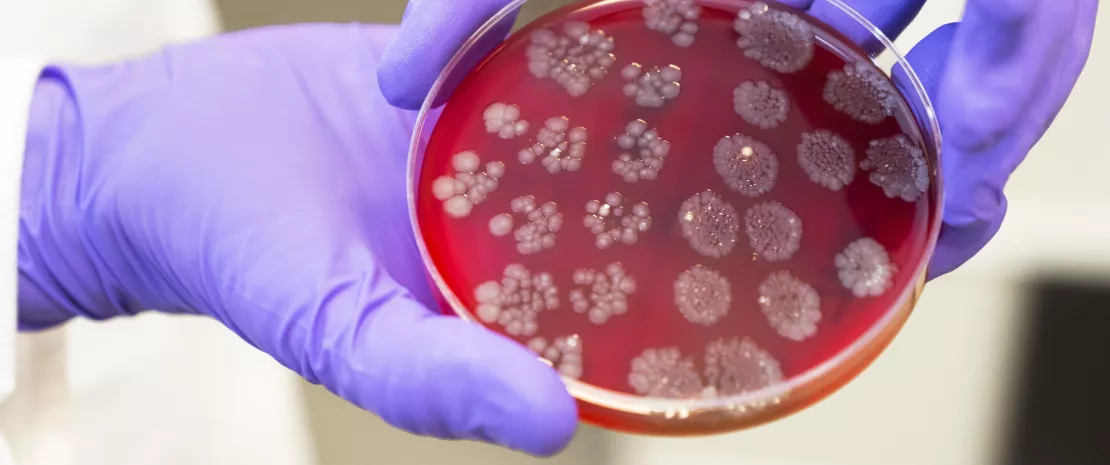

Transplantation de microbiote fécal : des résultats hétérogènes
Puisqu’une dysbiose intestinale semble associée aux MICI, la modulation du microbiote pourrait représenter une piste de prise en charge pertinente. Deux options possibles : la transplantation de microbiote fécal, ou le recours à des probiotiques.
en_sources_title
en_sources_text_start en_sources_text_end
Chapitres
Donor tests for faecal microbiota transplant. Researcher holding a petri dish culture from sample testing of a donor stool.
A propos de cet article
La transplantation de microbiote fécal permet d’apporter au patient approximativement 1011 bactéries par gramme de fèces, mais aussi des champignons, des virus et des archées. Objectif : corriger la dysbiose intestinale. Le nombre d’essais et les résultats diffèrent selon les individus et leur pathologie, et le protocole nécessite des contrôles sans faille13.
Moduler le microbiote intestinal représente un traitement potentiel des MICI. En pratique, cette stratégie peut être réalisée par transplantation de microbiote fécal (Fecal Microbiota Transplantation, ou FMT). La préparation de matière fécale provient d’un ou de plusieurs donneurs en bonne santé puis elle est transplantée dans le tractus gastro-intestinal distal d’un patient à l’aide d’une sonde nasogastrique, lors d’un lavement au cours d’une coloscopie, ou plus récemment par administration orale de gélules. Le protocole est déjà utilisé avec succès en cas d’infection récidivante à Clostridium difficile, mais qu’en est-il en cas de MICI ?
En cas de rectocolite hémorragique
Si les conditions de sécurité des premiers essais étaient satisfaisantes et que la thérapeutique apermis une rémission partielle ou totale chez certains patients souffrant de rectocolite hémorragique (RCH), d’autres tentatives furent plus controversées . La qualité de la composition fécale du donneur, le nombre de greffes et la précocité de la prise en charge pourraient moduler les chances de succès du protocole et expliquer, a posteriori, l’hétérogénéité des résultats14.
En cas de maladie de crohn (MC)
Les résultats des essais, moins nombreux, menés jusqu’à présent dans la maladie de Crohn (MC) ont révélé des résultats soit positifs (rémission clinique et endoscopique) soit nuls. Dans la seule étude qui ne met pas en évidence de réduction significative de la maladie, les patients rapportent néanmoins une amélioration de leur qualité de vie14. Pour confirmer l’efficacité clinique de la transplantation fécale dans la maladie, des études complémentaires demeurent encore nécessaires.
De nombreuses questions en suspens
Quelle que soit la maladie considérée, plusieurs questions restent en suspens. Elles concernent la prise de la greffe de microbiote, qui pourrait nécessiter des transplantations fécales multiples ; la qualité du microbiote implanté, souvent issu de donneurs vivant dans des pays où la prévalence des MICI est élevée ; la restauration des fonctions altérées du microbiote après la transplantation (par exemple la production d’acides gras à chaîne courte protecteurs comme le butyrate) ; sans oublier la place de l’inflammation, en tant que cause ou conséquence de la dysbiose14.